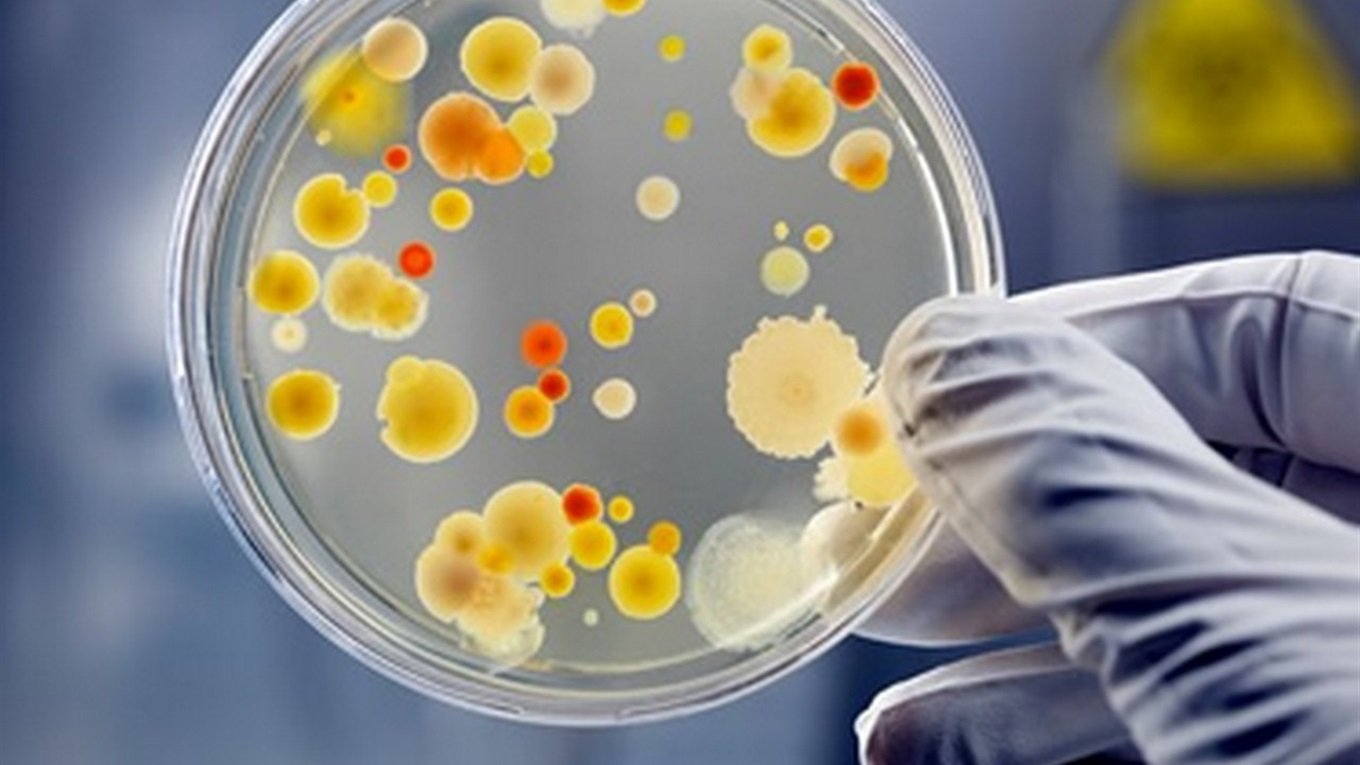

Краматорська районна філія ДУ «ДОНЕЦЬКИЙ ОЦКПХ МОЗ» надає інформацію щодо захворюваності кишковими інфекціями населення міста Краматорськ за минулий тиждень поточного року.
"За результатами щотижневого моніторингу інфекційної захворюваності на гострі кишкові інфекції в місті Краматорську з 25.08.2023 по 31.08.2023 (35-й тиждень року) зареєстровано 8 випадків гострої кишкової інфекції, інтенсивний показник 4,36 на 100 тис. населення та 2 випадки сальмонельозу (у дорослих) показник захворюваності становить 1,09 на 100 тис. населення.
В структурі захворюваності на кишкові інфекції на цьому тижні гастроентероколіти з невстановленим збудником регіструвались в 87,5% випадках і перевищили показник попереднього тижня на 18,5%. В порівнянні з 34-им тижнем показник захворюваності на ГЕК із встановленим збудником знизився в 3 рази.
Факторний аналіз ГEK показав дію харчового шляху передачі збудників кишкових інфекцій, який реалізувався через неправильне приготування, зберігання продуктів харчування в домашніх умовах та недотримання правил особистої гігієни.
Випадків дизентерії на цьому тижні не виявлено. В 50 % випадків захворюваність реєструвалася серед дитячого населення.
Фахівцями Краматорської районної філії у вогнищах інфекції проведено 10 епідеміологічних обстежень. За їх результатами здійснені відповідні санітарно-протиепідемічні та дезінфекційні заходи".